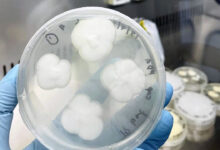

-
Puebla
Gobierno de la Ciudad refuerza limpieza preventiva para reducir riesgos de inundaciones durante temporada de lluvias
Puebla, Pue., 31 de mayo de 2026.- El Gobierno de la Ciudad mantiene una estrategia integral de prevención y atención ante la temporada de lluvias mediante acciones de limpieza, monitoreo y reducción de riesgos que buscan proteger la integridad y el patrimonio de las familias poblanas. A través del Comité de Fenómenos Hidrometeorológicos “Tláloc”, dependencias municipales trabajan de manera coordinada para identificar puntos vulnerables, fortalecer la capacidad de respuesta y disminuir las afectaciones derivadas de…
Leer más »